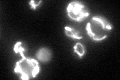
YOR286W

View description
Protein with rhodanese activity; contains a rhodanese-like domain similar to Rdl1p, Uba4p, Tum1p, and Ych1p; overexpression causes a cell cycle delay; null mutant displays elevated frequency of mitochondrial genome loss
Localization:
Intensity:
Fold change:
Significance:
-
C’ GFP library in SD
mitochondria75.84 -
N' NOP1pr-GFP in SD

mitochondria103.553 -
N' TEF2pr-mCherry in SD

mitochondria195.792 -
N' NATIVEpr-GFP in SD

cytosol,punctate25.1638 -
N' TEF2pr-VC and Cyto-VN in SD

#N/A0 -
C’ GFP library in SD+DTT

mitochondria84.031.1No -
C’ GFP library in SD+H2O2

mitochondria64.780.85No -
C’ GFP library in Starvation Media

mitochondria108.991.43Yes -
C’ GFP library on the background of Pup2-DaMP

mitochondria -
C’ GFP library on the background of CCT mutant

mitochondria69.37720.914715No
